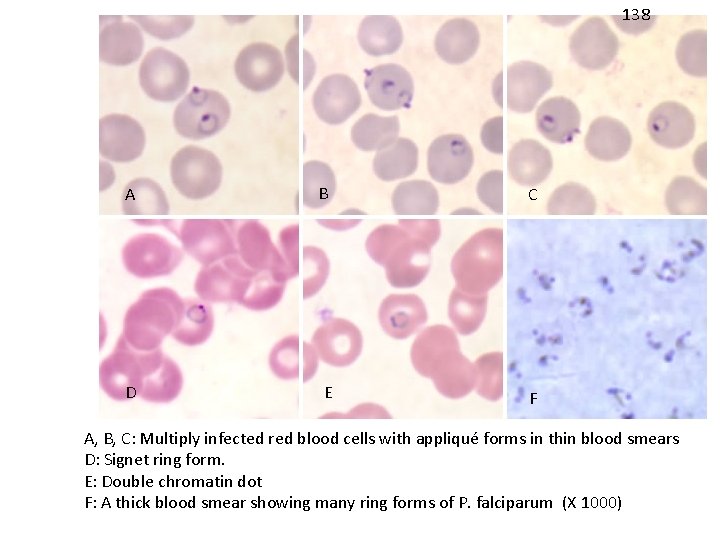
138 A B C D E F A, B, C: Multiply infected red blood

Protozoa Lab Plasmodium spp Part II Life Cycle

Protozoa

Lab. Plasmodium spp. Part II

Life Cycle: Tow transfers stages: sporozoite (from mosquito to man) & gametocytes (from man to mosquito)

1. Plasmodium vivax E. Ring stage (early trophozoite): Infected erythrocyte enlarged, Schüffner’s dots may be present Cytoplasm thin, enclosing a large vacuole, Light blue-gray; Nucleus single, staining red; Parasite resembling signet ring.

1. Plasmodium vivax F. Amoeboid stage(matyre trophozoite) Infected RBC enlarged; Schüffner’s dots present; Parasite occupying most of RBC; Shaped amoeboid; vacuoles several; Nucleus single. Early Late

1. Plasmodium vivax G. Schizont: Infected RBC enlarged; Schüffner’s dots present; Parasite occupying most of RBC; Nuclei 2 -24; Vacuoles absent. Merozoites Mature

P. vivax A C ( X 1000 ) 122 B D A, B: Mature schizonts C, D, E: Ruptured schizonts E

1. Plasmodium vivax H. Gametocytes: Infected RBC enlarged; Schüffner’s dots present; Parasite occupying most of RBC; Shape round; Nucleus single.

2. Plasmodium falciparum A. Ring stage (early trophozoite): Infected erythrocyte not enlarged, Schüffner’s dots absent; Slightly smaller Marginal forms Cytoplasm thin, enclosing a large vacuole, Nucleus single, or double (multiple infection) staining red; Parasite resembling signet ring.
138 A B C D E F A, B, C: Multiply infected red blood cells with appliqué forms in thin blood smears D: Signet ring form. E: Double chromatin dot F: A thick blood smear showing many ring forms of P. falciparum (X 1000)

2. Plasmodium falciparm B. Schizonts Not normally in peripheral circulation Compact parasite 16 -24 (up to 36) merozoites in infected RBC. Immature Mature

P. falciparum A C ( X 1000 ) B D A: Immature schizont in a thin blood smear. B: Mature schizont C, D: Ruptured schizonts in a thin blood smear

5. Plasmodium falciparum A. Gametocyte: Infected RBC not enlarged; Schüffner’s dots absent; Shape crescentic; Nucleus single. Microgametocytes with defuse nucleus, cytoplasm pale. Macrogametocytes with compact nucleus, cytoplasm stained deep blue. Macrogametocytes Microgametocytes

141 ( X 1000 ) A B D C E A, B, C, D: Gametocytes of P. falciparum in thin blood smears. Note the presence of a “Laveran’s bib”, which is not always visible E: Two gametocytes captured from a thick blood smear

4. Plasmodium malariae A. Band form: Infected RBC not enlarged; Schuffner’s dots absent; Cytoplasm compact, extending nearly along entire diameter of RBC; Nucleus single.

P. malariae ( X 1000 ) B A C A, B, C: Mature trophozoites in thin blood smears. A and B are band forms. C is a "basket" form
- Slides: 16